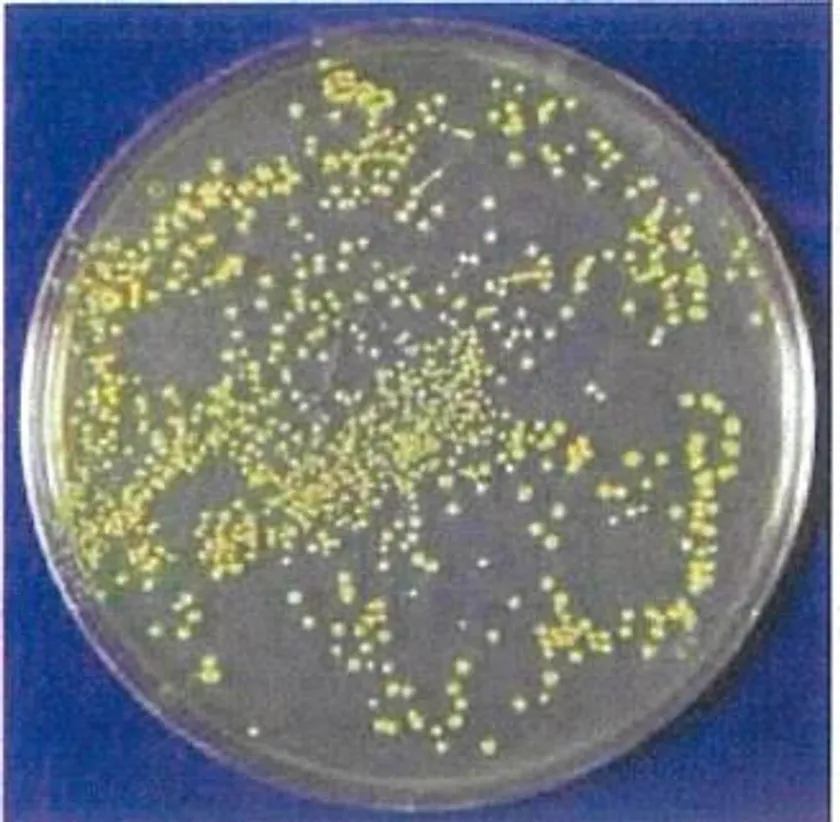
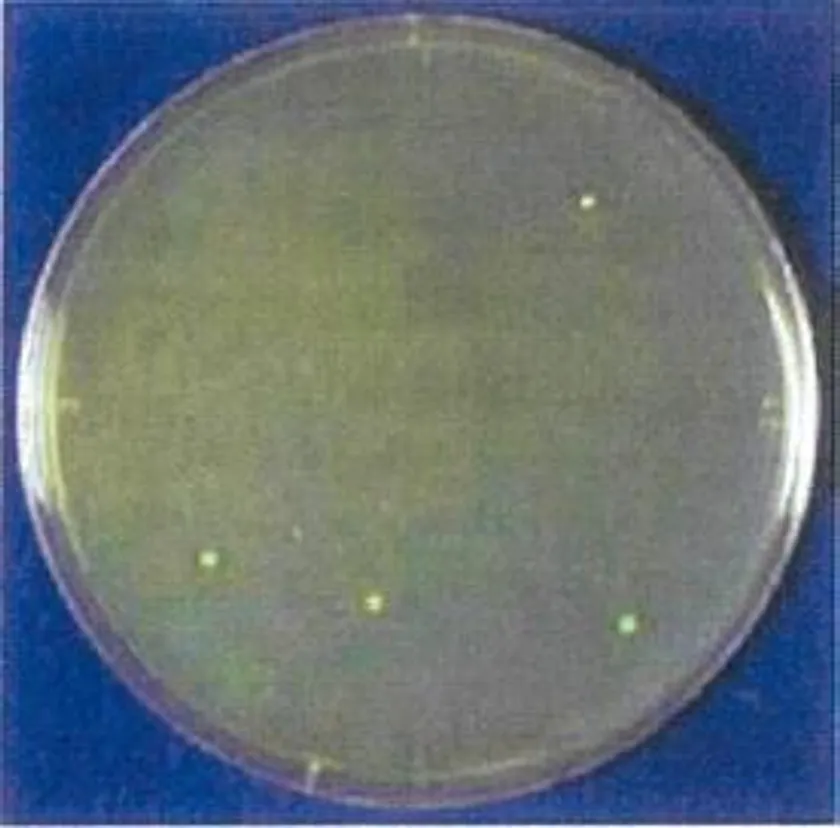

『小型空間殺菌装置』を開発し、5月よりサンプル製品を出荷 光による殺菌でウイルスの感染防止とオゾン発生が可能
~創業82年の電球会社が技術を生かし社会貢献~
世界で初めて胃カメラ用の電球を製作した細渕電球株式会社(本社:東京都荒川区、代表取締役:高橋 建志)は、光による殺菌でウイルスの感染防止とオゾン発生ができる『小型空間殺菌装置』を開発、2021年5月よりサンプル製品を出荷することをお知らせいたします。
『小型空間殺菌装置』は、オーダーメイドを可能にし、安全性を重視したオゾン(O3)センサーを標準装備し、人への安心・安全を提供します。付属のACアダプターを使用すれば、コンセントから電源を取ることができるので簡単設置・運用を可能にします。純国産冷陰極管は電球職人による手作りです。

小型空間殺菌装置
照射前 距離5cm
照射後 距離5cm
https://www.hosobuchi-lamp.co.jp/
■特徴
(1) 運用
クローゼット、トイレ、エレベーター内の空気を消臭・殺菌します。
(2) 冷陰極管
病原体破壊作用が最も高い254nm(UV-C)の波長を中心に照射。
(3) 光による殺菌
空気の循環による殺菌。
(4) オゾンによる消臭
同時に185nmの照射によりオゾンを発生し、消臭効果を発揮。
(5) 高品質
信頼と安心の日本品質(電球職人による手作り)。

冷陰極管 発光スペクトル
■開発の背景と展望
コロナ禍で感染者が増え続ける状況の中、電球会社として社会に貢献できることはないかと考えました。そこで当社は感染防止に向けた除菌対策に着目し、開発ターゲットとしました。また80年以上、手作り電球を作り続けておりますので、その技術を生かして本製品の商品化しました。より安全かつ高品質な商品を当社独自の蓄積してきた技術・経験をもとに創り出してまいります。
サンプル出荷:2021年5月より(価格未定)
■製品の特長・仕様
電源 :DC12V 7W(ACアダプターPSE認可済み)
大きさ :120W×70H×50D(mm)
重量 :250g
■会社概要
商号 : 細渕電球株式会社
本社 : 〒116-0013 東京都荒川区西日暮里1-27-12
代表 : 代表取締役 高橋 建志
創立 : 昭和23年12月
資本金 : 1,000万円
事業内容: 電球事業、LED電子事業、医療用機器事業など









![[愛鳥週間関連企画] 周南市徳山動物園「イロ鳥どり市」を開催](https://newscast.jp/attachments/IFmZtJzNJfCTbgTvpPZR.png)














